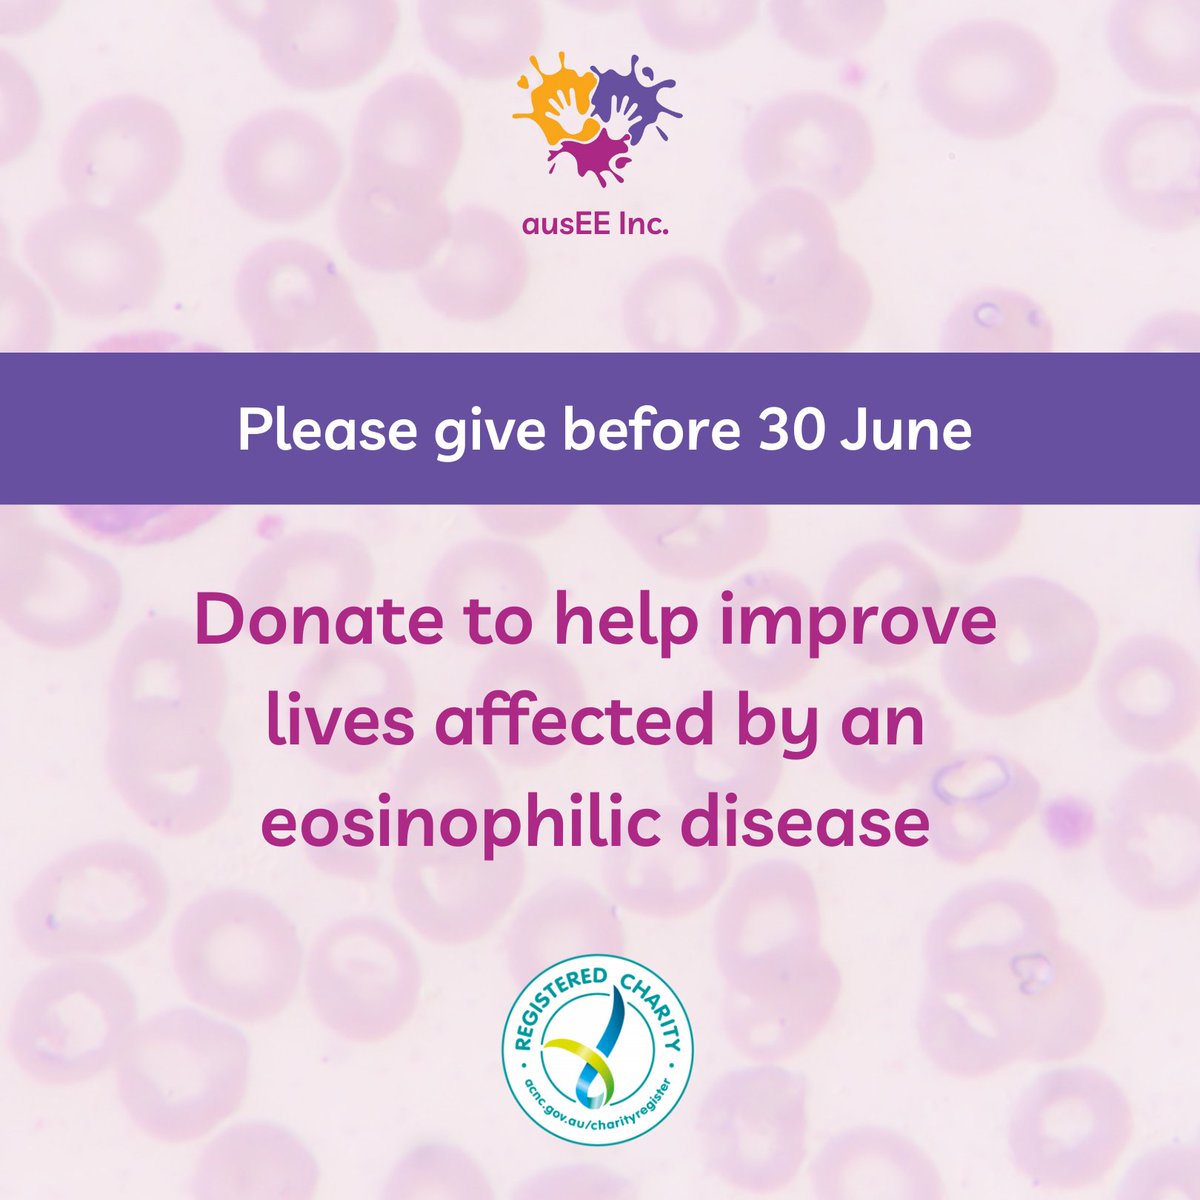

ausEE Inc.
@auseeorg
ausEE Inc. is Australia’s peak national support and patient advocacy organisation representing Australians living with an eosinophilic disease.
ID: 145754831
http://www.ausee.org 19-05-2010 20:04:38
2,2K Tweet
683 Takipçi
1,1K Takip Edilen





Are you a patient or caregiver with something to say? Make your voice heard by participating in paid surveys, interviews & online communities! ausEE is a referral partner of Rare Patient Voice & will receive a $10 contribution for every person who signs up: rarepatientvoice.com/rp/auseeinc



This week is World Allergy Week (29 June – 5 July 2025). This year’s theme is ‘Anaphylaxis: A Preventable Threat’. Learn more about #WorldAllergyWeek and register for the free webinar happening on 3 July on the World Allergy Organization website: worldallergyweek.org #WorldAllergyWeek2025












This week is National Pain Week (21-27 July 2025). Chronic Pain Australia has released the 2025 National Pain Report which underscores the profound impact of chronic pain on individuals, their loved ones, the community, the health system, and the economy: painchanger.org.au